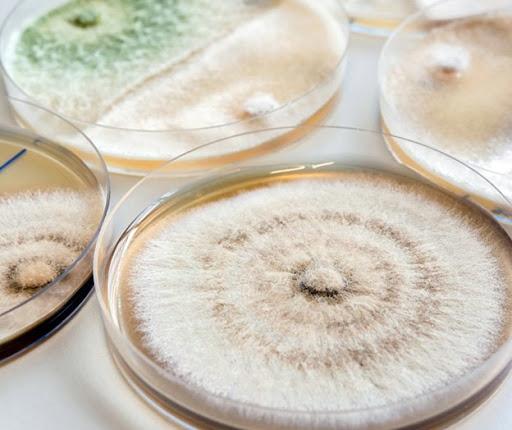

Diagnóstico de Hongos en Semilla, Suelo, Arena, Sustrato, Raíces, Césped y Agua
Los hongos fitopatógenos son una de las principales causas de deterioro en césped y superficies verdes, afectando directamente la estética, uniformidad y funcionalidad de campos de golf, áreas verdes y canchas deportivas. Su desarrollo puede verse favorecido por condiciones de alta humedad, deficiencias de drenaje, compactación del suelo y desequilibrios nutrimentales.
En Solmanag, ofrecemos un servicio especializado de diagnóstico de hongos en semilla, suelo, arena, sustrato, raíces, césped y agua, enfocado en la identificación oportuna del agente causal y en la interpretación técnica del problema, permitiendo establecer estrategias de manejo más precisas y eficientes.
Nuestro diagnóstico es una herramienta clave para evitar aplicaciones innecesarias, reducir riesgos fitosanitarios y mantener la calidad del césped en condiciones óptimas.
¿Qué incluye el servicio?
Análisis de muestras de:
Semilla
Suelo y arena
Sustratos
Raíces y tejido vegetal
Césped
Agua de riego
Identificación de hongos asociados a enfermedades del césped
Interpretación técnica de resultados
Recomendaciones generales para el manejo del problema detectado

Beneficios del diagnóstico de hongos
Identificación precisa del patógeno antes de aplicar tratamientos
Prevención de daños severos y propagación de enfermedades
Uso más eficiente y responsable de fungicidas
Reducción de costos operativos
Mejora en la calidad visual y funcional del césped
Apoyo técnico para decisiones de manejo sustentable
Aplicación del servicio
Este servicio está dirigido exclusivamente a campos de golf, áreas verdes, canchas deportivas y jardinería profesional, considerando las condiciones específicas de manejo, clima y uso intensivo del césped.
¿Presentas síntomas de enfermedades en el césped o problemas recurrentes en tus áreas verdes?
Solicita un diagnóstico especializado de hongos y toma decisiones técnicas con respaldo profesional.
